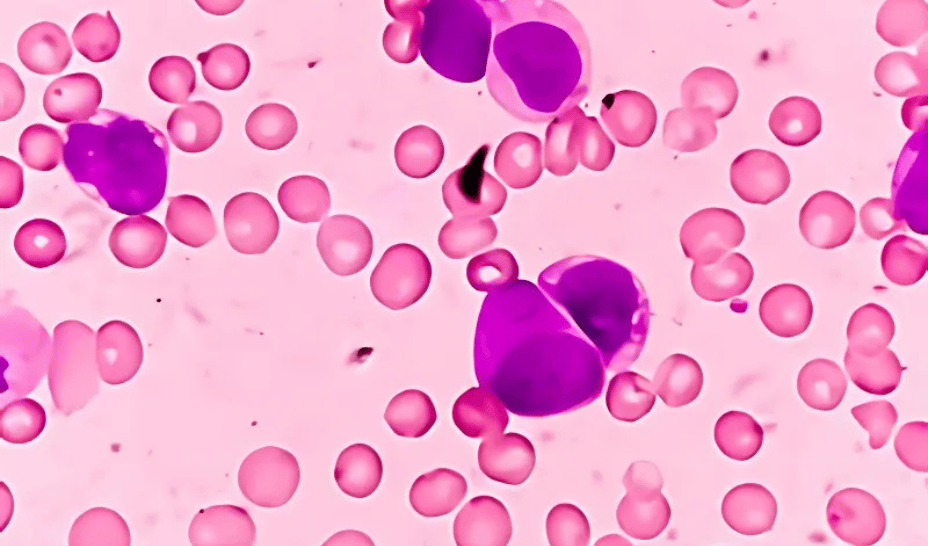

Hi {{ first name | there }} 👋
Welcome to this week’s HealthHack Newsletter, where breakthrough HealthTech meets what matters most: keeping you well, at home, and in control.
Whether it's smarter tools for managing heart failure, a sensor that could finally stop wasting transplantable kidneys, or wearable tech that picks up what your body might not be saying yet - this issue focuses on solutions that help you live longer and better.
We’ve also got new ways to spot hormone imbalances early and tech that can cut hospital visits down to size. If you’ve ever wished for more clarity in your care, this one's for you.
Let’s get into it.
EDITOR’S CHOICE ✨

Lunaris smart bionic limb bridges the gap between tech and touch
Axiles Bionics’ Lunaris isn’t just another prosthetic foot - it’s allegedly a leap forward in intuitive mobility. CE- and FDA-approved, it uses adaptive mechanics and embedded intelligence to replicate the smooth, natural motion of a human foot. For amputees, that means more confidence on stairs, slopes, and everyday terrain.
Now backed by €6 million in new funding, Lunaris is expanding globally, bringing lifelike movement to more patients than ever. It’s a milestone for robotic prosthetics - and a glimpse at a future where bionics don’t just restore motion, they restore freedom.
HealthTech That Feels Real
From synthetic skin that teaches surgeons to stretchable sensors that track your heart at home, these innovations blur the line between digital and physical.

Heart failure gets a wearable safety net
AIKON Health is building more than just infrastructure - it’s bringing cardiology home. They are rolling out a wearable system that tracks heart failure patients remotely, combining chest and arm sensors for continuous data collection via stretchable skin patches. The goal? Earlier interventions, fewer hospital readmissions, and better outcomes post-discharge.

Synthetic anatomy is here - and it’s eerily lifelike
AnthroTek is innovating medical simulation, prosthetics, and special effects with ultra-realistic silicone composites that mimic the look, feel, and behavior of real human tissue. Whether it’s for cadaver-free surgical training, sensory-rich robotics, or cinema prosthetics that fool the eye, they are setting new standards for synthetic anatomy.
Prevention & Precision
When prevention meets precision, the result is care that anticipates, not just reacts. From cleaner products to smarter farming, these innovations keep your health a step ahead.

Milk innovation for farmers that matters to you
Antler Bio’s gene expression tech boosts milk yield in dairy cows - but here’s why consumers should care: improved herd health, reduced waste, and more sustainable dairy means better quality and potentially healthier milk for you and your family.

Eco-friendly skincare that performs like a pro
Cellugy’s EcoFLEXY is a plant-based alternative to fossil-based carbomers - the hidden microplastics in your personal care products. Designed to outperform petrochemicals in feel and function, it’s set to remove over 1,200 tons of microplastics annually by 2034. Beauty that’s better for your skin and the planet.
VISIONARY VOICES 💬
Accunea’s kidney biosensor RenoSure speaks for the organ

1 in 5 donor kidneys get discarded out of caution - something Accunea’s RenoSure could change.
This small in-vitro biosensor aims to deliver real-time, objective readings of kidney function, offering transplant teams a new layer of insight they’ve never had before. For patients, this could unlock thousands more viable transplants and reduce dependence on dialysis - a treatment that often sustains, but rarely improves, quality of life.
With pilot trials expected by 2028, RenoSure could shift the global standard for what counts as a transplant-worthy organ.
Undiagnosed & Overlooked
When conditions go unseen, lives are cut short - not just in lifespan, but in quality. These two breakthroughs shine a spotlight on patients too often left behind: men suffering silent hormone crashes and leukemia patients facing relapse with few options.

Testosterone testing goes fully digital
Evaro has appointed Professor Geoffrey Hackett to help make at-home testosterone care a reality for millions of undiagnosed men. With 40% of men over 45 facing hormone deficiency linked to heart disease and depression, this platform uses AI-driven consultations and a nationwide phlebotomy network to diagnose and treat from home.
New hope for rare blood cancer patients
Priothera is advancing clinical trials for Mocravimod, a drug aimed at high-risk leukemia patients undergoing stem cell transplants. The therapy aims to help prevent disease relapse by modulating immune responses - potentially offering patients with few options a longer, healthier life.
Which frontier in care feels most urgent to you?
AI in Action
AI isn’t just theoretical - it’s already inside your healthcare experience. Here’s how it’s changing discovery, delivery, and even a few boundaries.

AI overhauls drug discovery with Predictive Genomics
Outsee is applying AI to predict effective compounds based on genomic data, making early-stage drug discovery faster and more precise. For patients, this could mean more effective therapies developed at a fraction of the typical timeline.

Voice AI looks to fix healthcare’s call center chaos
Superdials’ Voice AI aims to transform how we manage health insurance claims - no more endless phone menus or hang-ups. Smarter routing = fewer delays, headaches, and everything done in a conversational tone.
Well that’s it! 🚀
These innovations don’t just look impressive on paper - they have the power to directly improve outcomes for conditions that become more common with age.
Health is becoming less about the waiting room and more about real-time support, wherever you are.
Thanks for reading the HealthHack Newsletter - let us know which breakthroughs hit home for you, and we’ll be back with more next week.
Your HealthHack Team